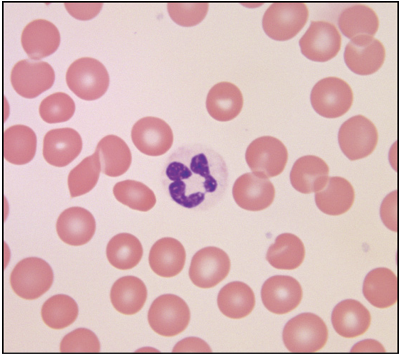
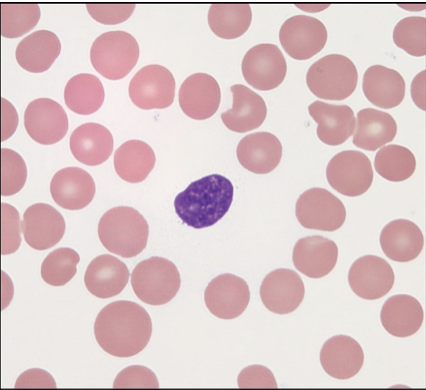
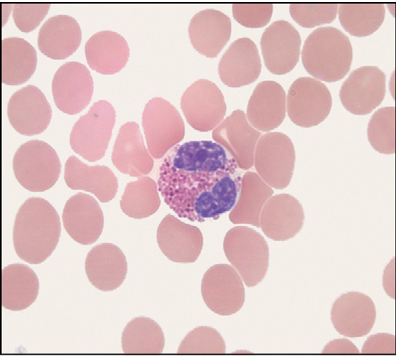
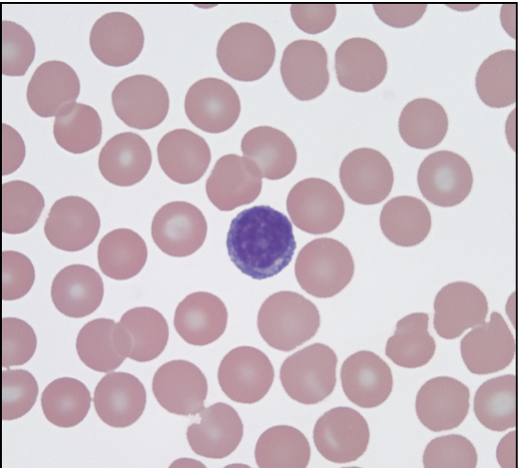
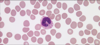

1
Q

A
simple columnar epithelium
2
Q

A
stratified squamous epithelium
3
Q

A
hyaline cartilage connective
4
Q

A
compact bone connective

5
Q

A
skelital muscle
6
Q

A
smooth muscle
7
Q

A
cardiac muscle
8
Q

A
spinal cord nervous
9
Q
label each part & type of cell

A
animal cell

10
Q

A
simple squamous epithelium
11
Q

A
simple cuboidal epithelium
12
Q

A
simple columnar epithelium
13
Q

A
stratified squamous layer epithelium
14
Q

A
hyaline cartilage connective
15
Q

A
elastic cartilage connective
16
Q

A
bone

17
Q

A
adipose tissue connective
18
Q

A
loose connective tissue
19
Q

A
dense connective tissue
20
Q
label from left to right

A
- leukocyte (white blood cell)
- platelet
- erythrocyte (red blood cell)
21
Q
A
neutrophil (type of leukocyte)
22
Q
A
basophil (type of leukocyte)
23
Q
A
eosinophil (type of leukocyte)
24
Q
A
Lymphocyte (type of leukocyte)
25
monocyte (type of leukocyte)
26

cardiac muscle
27

smooth muscle
28

skeletal muscle
29

nervous tissue

30
what phase is this cell in + label

early prophase
- spindle fibers
- nucleus with condensing chromosomes
31
what phase is this cell in + label

late prophase
- spindle fibers
- nucleus with condensing chromosomes
32
what phase is this cell in + label

metaphase
- spindle fibers
- metaphase plates
33
what phase is this cell in + label

anaphase
- separating chromosomes
34
what phase is this cell in + label

telophase
- decondensing chromsomes
- cleavage furrow
35
what phase is this cell in + label

cytokinesis
- daughter cell nucleus
- new plasma membrane
36

embryonic unfertilized sea star egg
37

embryonic fertilized sea star egg
38

embryonic 2 cell sea star
39

embryonic 4 cell sea star
40

embryonic 8 cell sea star
41

embryonic 16 cell sea star
42

embryonic 32 cell sea star
43

embryonic sea star blastula cell
44

late blastula of sea star cell
- blastocoel (fluid filled cavity)
45

early gastrula of sea star cell
- blastocoel
46
top to bottom

middle gastrula of sea star
- blastocoel (fluid filly cavity)
- blastopore (mouth like opening of the archenteron)
47

late gastrula of sea star
- archenteron
48

early bipinnaria larva of sea star
49

bipinnaria larva (ventral view)
50

bipinnaria larva (lateral view)


